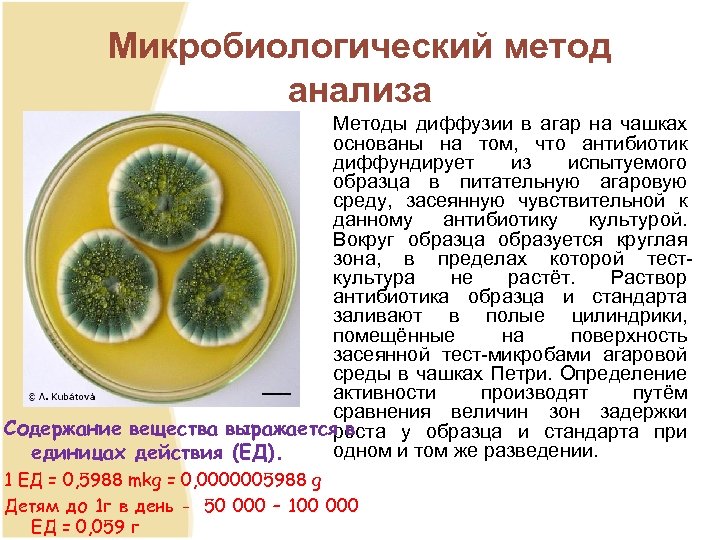
Микробиологический метод анализа Методы диффузии в агар на чашках основаны на том, что антибиотик

d6b1562862a73967d0f3339f6dca1bf1.ppt
- Количество слайдов: 70

Лекция № 8 Анализ производных β -лактамидов (пенициллинов и цефалоспоринов) Ташкент 2016

План: • Классификация антибиотиков • Анализ препаратов из группы беталактамидов • Анализ препаратов из группы цефалоспоринлар

Химиотерапия — лечение какого либо инфекционного, паразитарного или злокачественного заболевания с помощью ядов или токсинов, губительно воздействующих на инфекционный агент — возбудитель заболевания, на паразитов или на клетки злокачественных опухолей при сравнительно меньшем отрицательном воздействии на организм хозяина. Яд или токсин при этом называется химиопрепаратом, или химиотерапевтическим агентом. В отличие от фармакотерапии, в которой имеется всего два участника — фармакологический агент (лекарство) и подвергаемый его воздействию организм, в процессе химиотерапии имеется три участника — химиотерапевтический агент, организм хозяина и подлежащий убиению паразит, инфекционный агент или клон злокачественных опухолевых клеток.

Антибиотики вырабатываемые микроорганизмами химические вещества, которые способны тормозить рост и вызывать гибель бактерий и других микробов. Противомикробное действие антибиотиков имеет избирательный характер: на одни организмы они действуют сильнее, на другие - слабее или вообще не действуют.

за 1946 – 1950 г. г. было открыто около 200 антибиотиков, 1965 – 1970 г. г. – 1000, 1980 – 1985 г. г. – 2000, 1995 – 2000 г. г. – 3000. Однако внедрение антибиотиков в медицинскую практику падает. Если за: 1945 – 1975 г. г. практическое значение получили 1, 6% обнаруженных антибиотиков, то в 1975 – 2000 – только 0, 11%. В настоящее время известно около 12000 различ. антиб. Около 97% всех известных антибиотиков токсичны, в клинике применяется лишь около 200 соединений.


Классификация По характеру воздействия на бактериальную клетку антибиотики можно разделить на две группы: • бактериостатические (бактерии живы, но не в состоянии размножаться), • бактерицидные (бактерии погибают, а затем выводятся из организма).

Классификация



другие антибиотики • линкозамиды (линкомицин, клиндамицин); • анзамицины (рифампицин) • антрациклины (рубомицин, доксорубицин, карминомицин) • полиеновые антибиотики (нистатин, леворин макролиды) • гликопептиды (ванкомицин) и др.

β-лактамные антибиотики (β-лактамы) • — группа антибиотиков, которая объединяет наличие в структуре β лактамного кольца. К бета лактамам относятся подгруппы пенициллинов, цефалоспоринов, карбапенемов и монобактамов. Сходство химической структуры предопределяет одинаковый механизм действия всех β лактамов (нарушение синтеза клеточной стенки бактерий), а также перекрёстную аллергию к ним у некоторых пациентов. Механизм антибактериального действия β лактамилов состоит в блокировании конечной стадии образования стенки бактерий, которое вызывает лизис клетки. Под влиянием ферментов — лактамаз происходит процесс инактивации анти биотиков. Действие этих ингибиторов основано на конкурентном антагонизме с пенициллинами, поскольку и те и другие содержат β лактамное ядро.

Пенициллины получают из Penicillium chrysogenum ва Penicillium notatum путем биосинтеза

Технология получения пеницилинов • 1. В колбе проращивают споры тщательно отобранных, высоко продуктивных штаммов плесневых грибков. 2. Поскольку количество выращенной в колбе плесени невелико, ее продолжают выращивать в большей емкости малом ферментере. 3. Тем временем большой ферментер заполняют стерильной питательной средой, содержащей в нужном соотношении необходимые для роста плесени вещества. 4. Поскольку плесень для своего роста нуждается в кислороде, через ферментер пропускают стерильный воздух. 5. Содержимое малого ферментера переносится в производственный ферментер. Любые другие добавки предварительно стерилизуют, чтобы избежать загрязнения микробами, которые могут снизить выход антибиотика. 6. Когда выход антибиотика достигает максимума, содержимое ферментера поступает на вращающийся фильтр, где плесень отфильтровывается. 7. Фильтрат, содержащий пенициллин, поступает в емкость, куда добавляют химические реагенты, осаждающие антибиотик. 8. Затем смесь под давлением фильтруют, отделяя частично очищенный осажденный антибиотик от примесей, остающихся в растворе. 9. Осадок пенициллина подвергают дальнейшей обработке для удаления оставшихся примесей. 10. Очищенный кристаллический антибиотик центрифугируют и высушивают. 11. Расфасовка.

Выделение и очистка • Экстракция органическими растворителями • Сорбция • Осаждение и перекристаллизация из различных сред • Ионообменная хроматография • Сушка распылительная или лиофильная

Связь между химическим строением и биологическим действием пенициллинов

Препараты

Препараты

ПОЛУСИНТЕТИЧЕСКИЕ ПЕНИЦИЛЛИНЫ




ПОЛУСИНТЕТИЧЕСКИЕ ПЕНИЦИЛЛИНЫ

Белые кристаллические или мелкокристаллические по рошки, некоторые гигроскопичны. Соли хорошо растворяются, препараты со свободной карбоксильной группой мало растворяются в воде. Водные или спиртовые растворы враща ют плоскость поляризованного света вправо (за счет асимметрических атомов углерода 3, 5, 6 положениях). Бета-лактамное кольцо нестабилен, поэтому под действием кислот и щелочей, а также фермента пенициллиназа быстро разрушается :

Методы анализа Для оценки качества антибиотиков применяют: üхроматографические методы (ВЭЖХ, ТСХ на силикагеле Н или пластинках Сорбфил с по следующим проявлением в парах йода. ; ) üспектроскопические методы (ИК спектроскопия, УФ üспектроскопия) (ИК спектры природных и полусинтетических пенициллинов идентифицируют по совпадению с полосами поглощения соответствующих стандартных образцов в области 4000 400. см 1); üбиологические методы; üхимические методы (идентификация с помощью химических реакций, количественное определение титриметрическими методами и т. д. ).

Подлинность. Химические методы анализа 1. Гидроксамовая проба

Пенициллины с реактивом Марки образуют окрашенные в красный цвет продукты. Соли бензилпенициллина дают положительную реакцию Витали Морена подобно производным тропана. При выпаривании их с дымящей азотной кислотой и последующем прибавлении спиртового раствора гидроксида калия и ацетона появляется фиолетовое окрашивание. Если к раствору калиевой или натриевой соли бензилпенициллина при бавлять по каплям 25% ный раствор хлороводородной кислоты, то в осадок выпадает свободный бензилпенициллин, рас творимый в избытке хлороводородной кислоты, а также в этаноле, хлороформе, эфире. Соли бензилпенициллина при ки пячении в 4% ном растворе гидроксида натрия гидролизуются с образованием натриевой соли фенилуксусной кислоты, которая после добавления избытка разбавленной серной кислоты обнаруживается по характерному запаху. В МФ описаны способы установления подлинности пенициллинов, основанные на использовании в качестве реакти вапенициллиназы. Последняя, например, у бензилпенициллина новокаиновой соли вызывает изменение окраски раство ра нейтрального красного.

Реакция с хромотроповой кислотой в присутствии серной кислоты

Реакция на дибензилэтилендиамин

Феноксиметилпенициллин отличают от других пенициллинов по отрицательной реакции с концентрированной сер нойкислотой. Раствор остается бесцветным и после нагревания на водяной бане. Реактив Марки (раствор формальдеги да в концентрированной серной кислоте) используют для идентификации феноксиметилпенициллина. Наличие в его мо лекуле феноксиуксусной кислоты обусловливает реакцию гидролиза до фенола и гликолевой кислоты:


• Ампициллин и амоксациллин благодаря наличию в молекуле остатка аминокислоты дают положительную реакцию с нингидрином и с реактивом Фелинга подобно аминокислотам фиолетовое окрашива ние и красно кирпичный осадок.

Реакция на амоксициллин (ЗА СЧЕТ ФЕНОЛЬНОГО ГИДРОКСИЛА, ОТЛИЧИТЕЛЬНАЯ РЕАКЦИЯ ОТ АМПИЦИЛЛИНА)

Количественное определение • Йодометрический метод • кислотно основное титрование в водной среде • кислотно основное титрование в неводных средах (ампициллин) • биологический метод

Количественное определение по ГФ 10



Гравиметрия

Кислотно основное титрование в водной среде Сумму полусинтетических пенициллинов в натриевой соли оксациллина и динатриевой соли карбенициллина опреде ляют методом обратной нейтрализации. В его основе лежит количественно происходящий при нагревании на водяной ба не процесс гидролиза 0, 1 М раствором гидроксида натрия до образования производных пенициллоиновой кислоты: Ind. фенолфталеин

КО дибензилэтилендиамина В бицилине

Неводное титрование (ампициллин)

Неводное титрование (феноксиметилпициллин)

БП новокаиновая соль

Европейская фармакопея. ВЭЖХ

Британская Фармакопея

Индийская фармакопея. УФ спектрофотометрия

Микробиологический метод анализа Методы диффузии в агар на чашках основаны на том, что антибиотик диффундирует из испытуемого образца в питательную агаровую среду, засеянную чувствительной к данному антибиотику культурой. Вокруг образца образуется круглая зона, в пределах которой тест культура не растёт. Раствор антибиотика образца и стандарта заливают в полые цилиндрики, помещённые на поверхность засеянной тест микробами агаровой среды в чашках Петри. Определение активности производят путём сравнения величин зон задержки Содержание вещества выражается в роста у образца и стандарта при одном и том же разведении. единицах действия (ЕД). 1 ЕД = 0, 5988 mkg = 0, 0000005988 g Детям до 1 г в день - 50 000 – 100 000 ЕД = 0, 059 г


Препараты группы цефалоспоринов 1 поколение Цефазолина натриевая соль 2 поколение 3 и 4 поколение Цефуроксим Цефалотина натриевая соль Цефалексин цефадроксил Цефатаксим Цефтриаксон цефаперазон цефаклор Сульперазон Цефодизим Цефтазидим



ЦЕФАЛОСПОРИН. Производное 7 - АЦК

Методы анализа чинлиги тозалиги Миқдори • Мис ёки темир гидроксаматлари • Натрий ионига • ИК спектроскопия • УФ спектрофотометрия (цефалексин – 260 нм; цефалотин натрий – 237 нм) • ВЭЖХ • УФ спектрофотометрия • ВЭЖХ фенилглицин • ГЖХ – диметиланилин ва колган эритувчилар (ацетон, этанол, метанол, этилацетат) • Йодометрия • Сувсиз мухитда кислота асос титрлаш • УФ спектрофотометрия (20 мкг/мл) • ВЭЖХ • Биологик усул

Количественное определение

Спецификация качества по ФС США подлинность • ТСХ – бутилацетат: бутиловый спирт: уксусная к та: фосфатный буфер р. Н 6, 0 (50: 9: 25: 15). Пары йода Чистота • ВЭЖХ • Прозрачность • Цветность • Пирогенность • р. Н (5, 0 7, 0) • Токсичность • Вода К. Фишер Количественное определение • Фармакопея США – ВЭЖХ. ПФ – 0, 005 М раствора тетрабутиламмония гидроксида в ацетонитриле. УФ детектор – 230 нм.

Антибиотики-аминоглкозиды 2. Сахарная часть стрептобиозамин (N метил – L глюкозамин и L стрептоза) Streptomycin sulfate 1. Агликон – стрептидин (1, 3 дигуанидино 2, 4, 5, 6 тетраоксициклогексан или спирт инозит) гуанидин

Получение Штаммы Actinomyces streptomycini и др. Метод ферментация Свойства препарата • Порошок белого цвета или почти белого цвета без запаха. Гигроскопичен. Легко растворим в воде, практически нерастворим в органических растворителях. • Обладает основным характером, образует соли. В слабо кислой среде устойчив, под действием сильных кислот легко гидролизуется на агликон и сахарные части ( ). • Под действием щелочей инактивируется за счет дегидратации и изомеризации стрептозы, которая превращается в мальтол (α метил β –окси γ пирон)

Подлинность 1. На альдегидную группу: • Образование мальтола • • • раствором Фелинга реактивом Несслера резорцином в присутствии серной кислоты


Подлинность 2. На гуанидиновый цикл: • с гипобромидом натрия и α нафтолом (окисление и бромирование) • нитропруссидом натрия • выделение аммиака под действием щелочи 3. На сульфат ион 4. С пикриновой кислотой




Антибиотики гликозиды Kanamycin sulfate Gentamycin sulfate Amikacin sulfate Белый кристаллический порошок без запаха, гигроскопичен. Удельное вращение от +103 до +1150 (5% водный раствор). Легко растворим в воде, практически не растворим в органических растворителях Белый порошок с кремовым оттенком, гигроскопичен. Удельное вращение от +107 до +1210 (1% водный раствор ) Легко растворим в воде, практически не растворим в органических растворителях Белый аморфный или с кремовым оттенком порошок. Удельное вращение от +74 до +840 (2% водный раствор ) Легко растворим в воде, практически не растворим в органических растворителях

Подлинность препаратов Kanamycin sulfate Gentamycin sulfate Amikacin sulfate • На сахарный часть (образование фурфурола): орцин (или α нафтол) в присутствии HCl и железа хлорида (III) • 0, 2% р р нингидрина в смеси бутанола и пиридина(фиолетово е окрашивание) • ТСХ (нингидрин) • 0, 2% р р нингидрина в смеси бутанола и пиридина(фиолетово е окрашивание) • ТСХ (пары йода) • ПМР спектроскопия • ВЭЖХ (С 1 от 25 до 50%; С 1 а от 10 до 35%; сумма С 2 и С 2 а от 25 до 55%) • С антроном (голубовато фиолетовое окрашивание) • Со щелочью и кобальта нитрата (фиолетовое окрашивание) • 0, 2% р р нингидрина в смеси бутанола и пиридина(фиолетово е окрашивание) • ТСХ (нингидрин)

Реакция на амикацин (конц. минерал. кислотами)

Количественное определение препаратов Канамицина сульфат Гентамицина сульфат Амикацин сульфат • Биологический метод • ВЭЖХ • Гравиметрически • Трилонометрически • Полярометрически • ФЭК (с меди сульфат в щелочной среде или салици ловым альдегидом) • Спектрофотометрия • ВЭЖХ (С 1 от 25 до 50%; С 1 а от 10 до 35%; сумма С 2 и С 2 а от 25 до 55%) • Биологический метод • ВЭЖХ • Гравиметрически • Трилонометрически

Применение • Бета лактамные антибиотики, делящиеся на две подгруппы: • Пенициллины — вырабатываются колониями плесневого грибка Penicillinum; • Цефалоспорины — обладают схожей структурой с пеницилли нами. Используются по отношению к пенициллинустойчивым бактериям. • Макролиды — антибиотики со сложной циклической структурой. Действие — бактериостатическое. • Тетрациклины — используются для лечения инфекций дыхатель ных и мочевыводящих путей, лечения тяжелых инфекций типа сибирской язвы, туляремии, бруцеллёза. Действие — бактериостатическое. • Аминогликозиды — обладают высокой токсичностью. Использу ются для лечения тяжелых инфекций типа заражения крови или перитонитов. Действие — бактерицидное. • Левомицетины — Использование ограничено по причине повышенной опасности серьезных осложнений — поражении костного мозга, вырабатывающего клетки крови. Действие — бактериостатическое. • Гликопептидные антибиотики нарушают синтез клеточной стенки бактерий. Оказывают бактерицидное действие, однако в отноше нии энтерококков, некоторых стрептококков и стафилококков действуют бактериостатически.

Применение • Линкозамиды оказывают бактериостатическое действие, которое обусловлено ингибированием синтеза белка рибосомами. В высоких концентрациях в отношении высокочувствительных микроорга низмов могут проявлять бактерицидный эффект. • Антибиотики разных групп — Рифамицин, Ристомицина сульфат, Фузидин натрий, Полимиксина M сульфат, Полимиксина B сульфат, Грамицидин, Гелиомицин. • Противогрибковые препараты — разрушают мембрану клеток грибков и вызывают их гибель. Действие — литическое. Постепенно вытесняются высокоэффективными синтетическими противогриб ковыми препаратами. • Противолепрозные препараты — Диафенилсульфон, Солюсульфон, Диуцифон.
d6b1562862a73967d0f3339f6dca1bf1.ppt